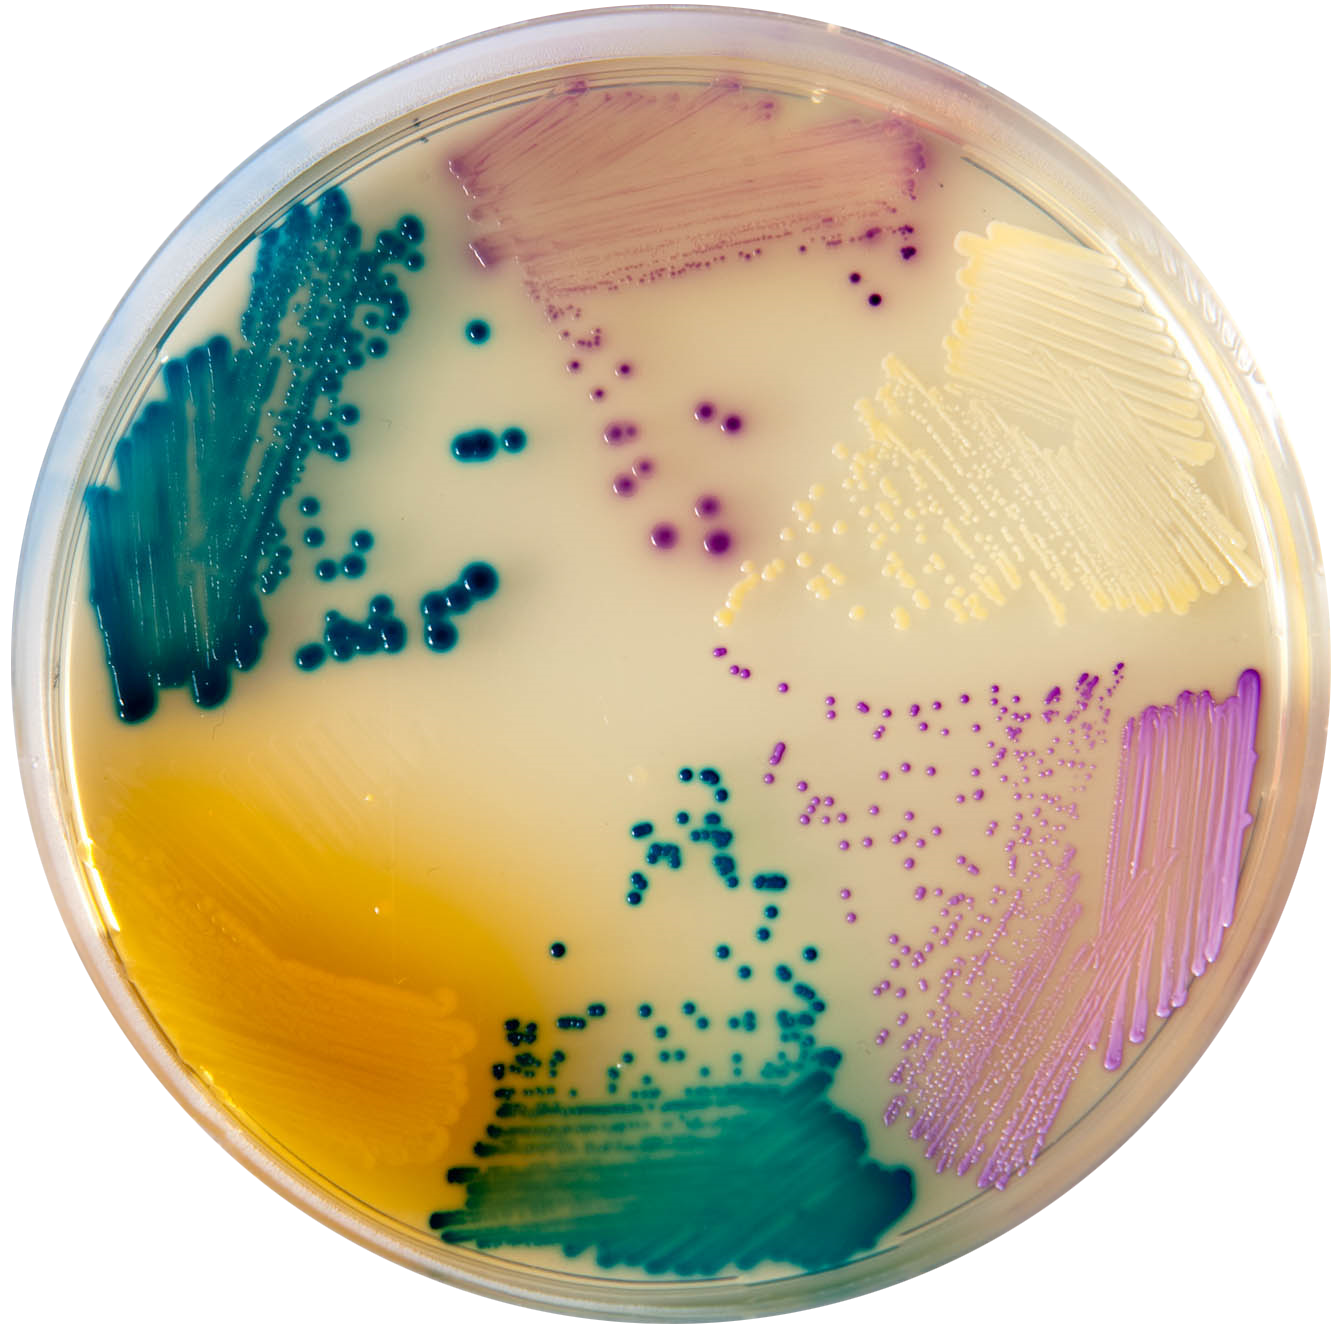
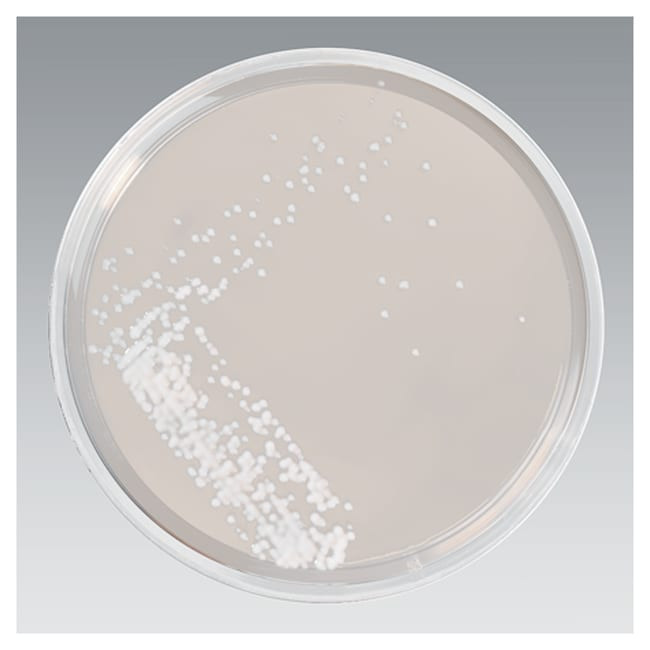

Кандида агар
Кандида агар 114 фото
Крымск улицы с номерами домов
Песня высоцкого про треугольник
Хороший доктор история
Лучшая система от протечек
Прослушивания в шербакуле
Улица проспект патриотов
Гимнастический лосины
Машина хотпоинт аристон не отжимает
Морской мегалодон
Герои тайны следствия